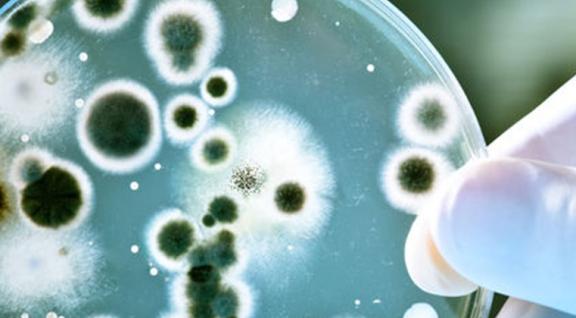
Kennisbericht antibioticaresistentie

Verslag symposium online: Nuance uitdaging in belangafwegingen omgeving en veehouderij
Om het integraal denken op gang te brengen en te houden, moeten we vooral over onze eigen schaduw heen stappen.

Om het integraal denken op gang te brengen en te houden, moeten we vooral over onze eigen schaduw heen stappen.



Eind 2020 organiseerde het Kennisplatform de webinar Ammoniak en fijnstof in relatie tot veehouderij en gezondheid.

Het Kennisplatform heeft een nieuw onderwerp opgenomen op de website: Rundveehouderijen.

Eerdere VGO-onderzoeken tonen aan dat er een hogere kans is op longontsteking voor omwonenden nabij een geitenhouderij. Waardoor dit zou kunnen komen, wordt onderzocht in VGO-3.



In dit vernieuwde kennisbericht ligt de focus bij het risico op humane besmetting via de veehouderij, waarbij tevens de context met de andere bronnen (potentiële reservoirs van resiste
Het Kennisplatform heeft het Kennisbericht Geur ge-update.
